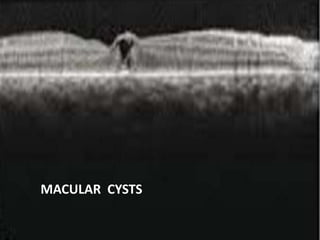
MACULAR HOLE
• A: Stage 1- Foveal pseudocyst;
• B: Stage 2- Full thickness macular hole (FTMH) with foveal vitreous
attachment;
• C: Stage FTMH with operculum and limited PVD (note papillary vitreous
attachment);
• D: Stage 4- FTMH with complete PVD
MACULAR CYSTS
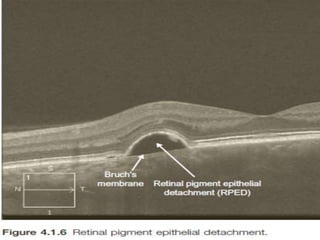
RETINAL PIGMENT EPITHELIAL
DETACHMENT
• This is noted as a dome-shaped separation of the RPE
from the underlying Bruch’s membrane.
• The space between the RPE and the Bruch’s membrane
is hyporeflective.
• The differential diagnosis includes:
▶ Age-related macular degeneration
▶ Central serous chorioretinopathy
▶ Choroidal neovascularization (e.g myopic degeneration,
presumed ocular histoplasmosis,angioid streaks)
▶ Idiopathic
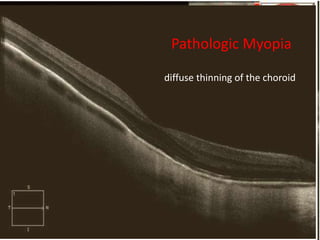
Atrophy of RPE
• causes decreased absorption of light. The OCT signal
penetrate more deeply, which exaggerates the typical
signal pattern : ‘reverse’ shadowing effect
• The differential diagnosis includes:
▶ Geographic atrophy
▶ Advanced chorioretinal scarring secondary to retinal
degenerations and macular dytrophies
(retinitis pigmentosa, Stargardt’s disease, cone dystrophy)
▶ Chorioretinal atrophy secondary to inflammatory
disorders (ocular histoplasmosis,multifocal choroiditis)
▶ Severe myopic degeneration
▶ Angioid streaks.
retinitis pigmentosa
Pathologic Myopia
diffuse thinning of the choroid
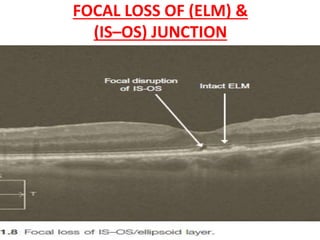
FOCAL LOSS OF (ELM) &
(IS–OS) JUNCTION
• severe outer retinal conditions such as cone
dystrophy, solar retinopathy
• inner retinal disorders when they advance to
involving the outer retinal layers.

Optical coherence tomography (OCT) provides high resolution, cross-sectional images of the retina. OCT uses light waves to generate tomographic scans. Early OCT systems had axial resolutions of 10 μm and scan speeds of 400 scans/second. Newer spectral domain OCT systems have higher resolutions of 1-15 μm and faster scan speeds of up to 52,000 scans/second, allowing better visualization of retinal layers and pathology. OCT is used to qualitatively and quantitatively evaluate retinal morphology and thickness.